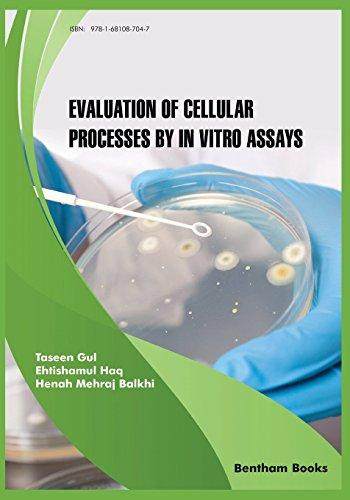
国外库房发货，通常付款后5-8周到货！

![【3-4周达】Beginning Scala 3: A Functional and Object Oriented Java Language: From Beginner to Pro [9781484274217] - 封面](https://img.alicdn.com/bao/uploaded/i3/2107887916/O1CN01O4RrKu28LaMYpgh5H_!!4611686018427384108-0-item_pic.jpg_500x500q90)
![【3-4周达】Beginning Scala 3: A Functional and Object Oriented Java Language: From Beginner to Pro [9781484274217] - 图0](https://img.alicdn.com/i3/2107887916/O1CN01Xn0XtS28LaIbVZfrc-2107887916.jpg_500x500q90)
![【3-4周达】Beginning Scala 3: A Functional and Object Oriented Java Language: From Beginner to Pro [9781484274217] - 图1](https://img.alicdn.com/i4/2107887916/O1CN01WxnIwa28LaIakhcfO-2107887916.jpg_500x500q90)
【3-4周达】Beginning Scala 3: A Functional and Object Oriented Java Language: From Beginner to Pro [9781484274217]
店铺:澜瑞图书专营店 品牌:澜瑞图书专营店 地址:江苏 苏州 商城:天猫
![【3-4周达】Beginning Scala 3: A Functional and Object Oriented Java Language: From Beginner to Pro [9781484274217] - 封面](https://img.alicdn.com/bao/uploaded/i3/2107887916/O1CN01O4RrKu28LaMYpgh5H_!!4611686018427384108-0-item_pic.jpg_500x500q90)
![【3-4周达】Beginning Scala 3: A Functional and Object Oriented Java Language: From Beginner to Pro [9781484274217] - 图0](https://img.alicdn.com/i3/2107887916/O1CN01Xn0XtS28LaIbVZfrc-2107887916.jpg_500x500q90)
![【3-4周达】Beginning Scala 3: A Functional and Object Oriented Java Language: From Beginner to Pro [9781484274217] - 图1](https://img.alicdn.com/i4/2107887916/O1CN01WxnIwa28LaIakhcfO-2107887916.jpg_500x500q90)
店铺:澜瑞图书专营店 品牌:澜瑞图书专营店 地址:江苏 苏州 商城:天猫
![【3-4周达】Beginning Scala 3: A Functional and Object Oriented Java Language: From Beginner to Pro [9781484274217]](https://img.alicdn.com/bao/uploaded/i3/2107887916/O1CN01O4RrKu28LaMYpgh5H_!!4611686018427384108-0-item_pic.jpg_500x500q90)
【3-4周达】Beginning Scala 3: A Functional and Object Oriented Java Language: From Beginner to Pro [9781484274217]

创新者的窘境(珍藏版)克莱顿克里斯坦森著创新者的任务创新者的路径繁荣的悖论企业管理创新者系列传世管理经典创新能力中信图书

2025年枣庄滕州高级技工学校招聘公共基础知识和教学基础知识笔试面试考试真题复习资料大石头题库

现货 漫爵 Fate/staynight Unlimited Blade Works 4 台版漫画书 角川 森山大辅 TYPE-MOON繁体中文

预订 Knautia Perfect Perennial Cut Flowers: Become flowers expert: 9798873095643

空气炸锅专用食谱低油好吃

庞中华楷书书体练习字帖 现代格言楷书硬笔字帖 作者 庞中华 西南师范大学出版社

预订 Adult Dyslexia Interventions: A Comprehensive Guide to Thriving with Dyslexia as an Adult: 9798335794855

【预售】Der Feste Grund Des Unberechenbaren: Georg Simmel

预售 撬动宇宙的那一刻,那些看似不起眼的发现瞬间:从古代智慧到现代技术,关键时刻的灵光乍现,竟推动人类文明 崧烨文化 陈劭
![【3-4周达】Beginning Scala 3: A Functional and Object Oriented Java Language: From Beginner to Pro [9781484274217]](https://img.alicdn.com/bao/uploaded/i3/2107887916/O1CN01O4RrKu28LaMYpgh5H_!!4611686018427384108-0-item_pic.jpg_500x500q90) 书籍/杂志/报纸
582
官方立减
书籍/杂志/报纸
582
官方立减
天猫好物 书籍/杂志/报纸
优惠80元 预订商品
182
券后价
预订商品
182
券后价
天猫好物 书籍/杂志/报纸
16元优惠券 预订商品
631
券后价
预订商品
631
券后价
天猫好物 书籍/杂志/报纸
34元优惠券 国外库房发货,通常付款后5-8周到货!
840
券后价
国外库房发货,通常付款后5-8周到货!
840
券后价
天猫好物 书籍/杂志/报纸
80元优惠券 国外库房发货,通常付款后5-8周到货!
682
券后价
国外库房发货,通常付款后5-8周到货!
682
券后价
天猫好物 书籍/杂志/报纸
34元优惠券![【3-4周达】Lessons from An Early Career Therapist: Managing Mistakes, Missteps, and Other Minor Disas... [9781032409283]](https://img.alicdn.com/bao/uploaded/i4/2107887916/O1CN01RyFYIR28LaLroSZVZ_!!4611686018427384108-0-item_pic.jpg_500x500q90) 书籍/杂志/报纸
1644
官方立减
书籍/杂志/报纸
1644
官方立减
天猫好物 书籍/杂志/报纸
优惠225元 预订商品
160
券后价
预订商品
160
券后价
天猫好物 书籍/杂志/报纸
16元优惠券 书籍/杂志/报纸
476
券后价
书籍/杂志/报纸
476
券后价
天猫好物 书籍/杂志/报纸
10元优惠券 书籍/杂志/报纸
840
券后价
书籍/杂志/报纸
840
券后价
天猫好物 书籍/杂志/报纸
30元优惠券![预订 Conductometric titration of metal complexes [9783659749452]](https://img.alicdn.com/bao/uploaded/i3/2107887916/O1CN018KqQQk28LaMm1ftVi_!!4611686018427384108-0-item_pic.jpg_500x500q90) 书籍/杂志/报纸
491
官方立减
书籍/杂志/报纸
491
官方立减
天猫好物 书籍/杂志/报纸
优惠68元